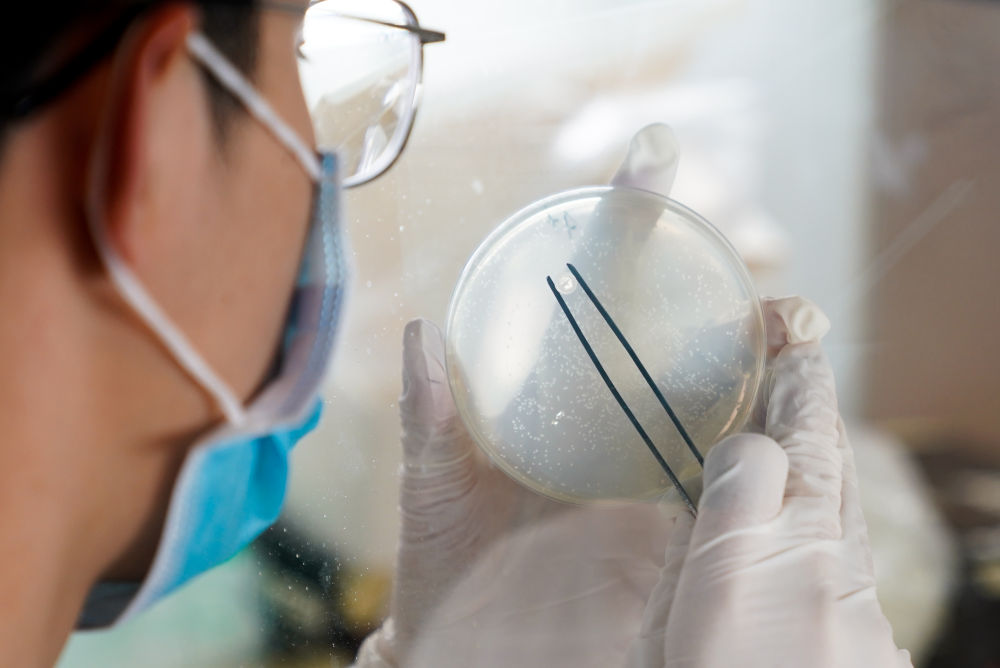

“今天是新年第一个工作日,你会怎么过?”记者问。
“我大概还是和昨天一样过。”赵耀回答。
1月4日,在上海科技大学免疫化学研究所,科研人员在实验室内进行研发工作。新华社记者 丁汀 摄
4日上午9时,记者来到上海科技大学免疫化学研究所时,31岁的副研究员赵耀已经忙碌多时。在电脑上修改完一篇学术论文后,他换上工作服,走进实验室,埋头继续进行抗新冠肺炎新药的研发工作。
赵耀是上海科技大学抗新冠病毒联合攻关团队的主要成员之一。疫情暴发后,该团队在国际上率先成功解析新冠病毒关键药物靶点——主蛋白酶的高分辨率三维空间结构,并提前向国内外300多所高校、研究机构及企业的实验室分享实验数据,为全球迅速研发具有临床潜力的抗新冠肺炎药物奠定了重要基础。
赵耀解释说,主蛋白酶是新冠病毒为在人体内自我复制所必需的一个关键酶,破解其三维空间结构,就能为研发新药提供关键依据。
1月4日,在上海科技大学免疫化学研究所,科研人员在实验室内进行研发工作。新华社记者 丁汀 摄
“2021年,我们将继续做好新药研发工作,争取获得针对新冠病毒主蛋白酶的全新抑制剂,并开展相应的临床前预试验。”赵耀表示,团队坚定地推进这项工作,也是在汲取SARS研究的经验。“非典疫情过去后,不少相关药物研究也随之遇冷,但新冠肺炎疫情又敲响了一次警钟,其实重大传染病一直没有远离我们,在药物研发上,必须未雨绸缪。”
为此,赵耀和同事们片刻不停歇。3日,他的工作是去上海同步辐射光源收集新冠病毒主蛋白酶晶体衍射数据;2日,他同样在所里加班,准备好了3日研究所需的蛋白质晶体样品。
过去一年,赵耀胖了二十多斤。“形势催着人跑,加班多了许多,经常熬夜,在超高的压力下饿了总忍不住吃夜宵,就这么胖起来了。”
新的一年,赵耀期待更多获得感。“突然暴发的疫情,客观上让我们的多年所学有了一个实战的机会,同时也把我们青年科研人员推到了国际竞争的前台。面向新一年,面向国家重大需求,我们要肩负起历史责任,当好科技创新排头兵,拿出看得远、站得住的基础研究成果。”
1月4日,在上海科技大学免疫化学研究所,科研人员在实验室内进行研发工作。新华社记者 丁汀 摄
据了解,近年来,上海科技大学瞄准物质科学与技术、生命科学与技术及信息科学与技术的前沿领域,开展了多项围绕国家经济社会发展战略的团队科研,相继取得丰硕成果。
新华社客户端上海1月5日电(记者吴振东、丁汀)
来源:新华社上海分社
原文链接:“形势催着人跑” 看青年科学家的“开工”首日 - 新华社客户端 (zhongguowangshi.com)